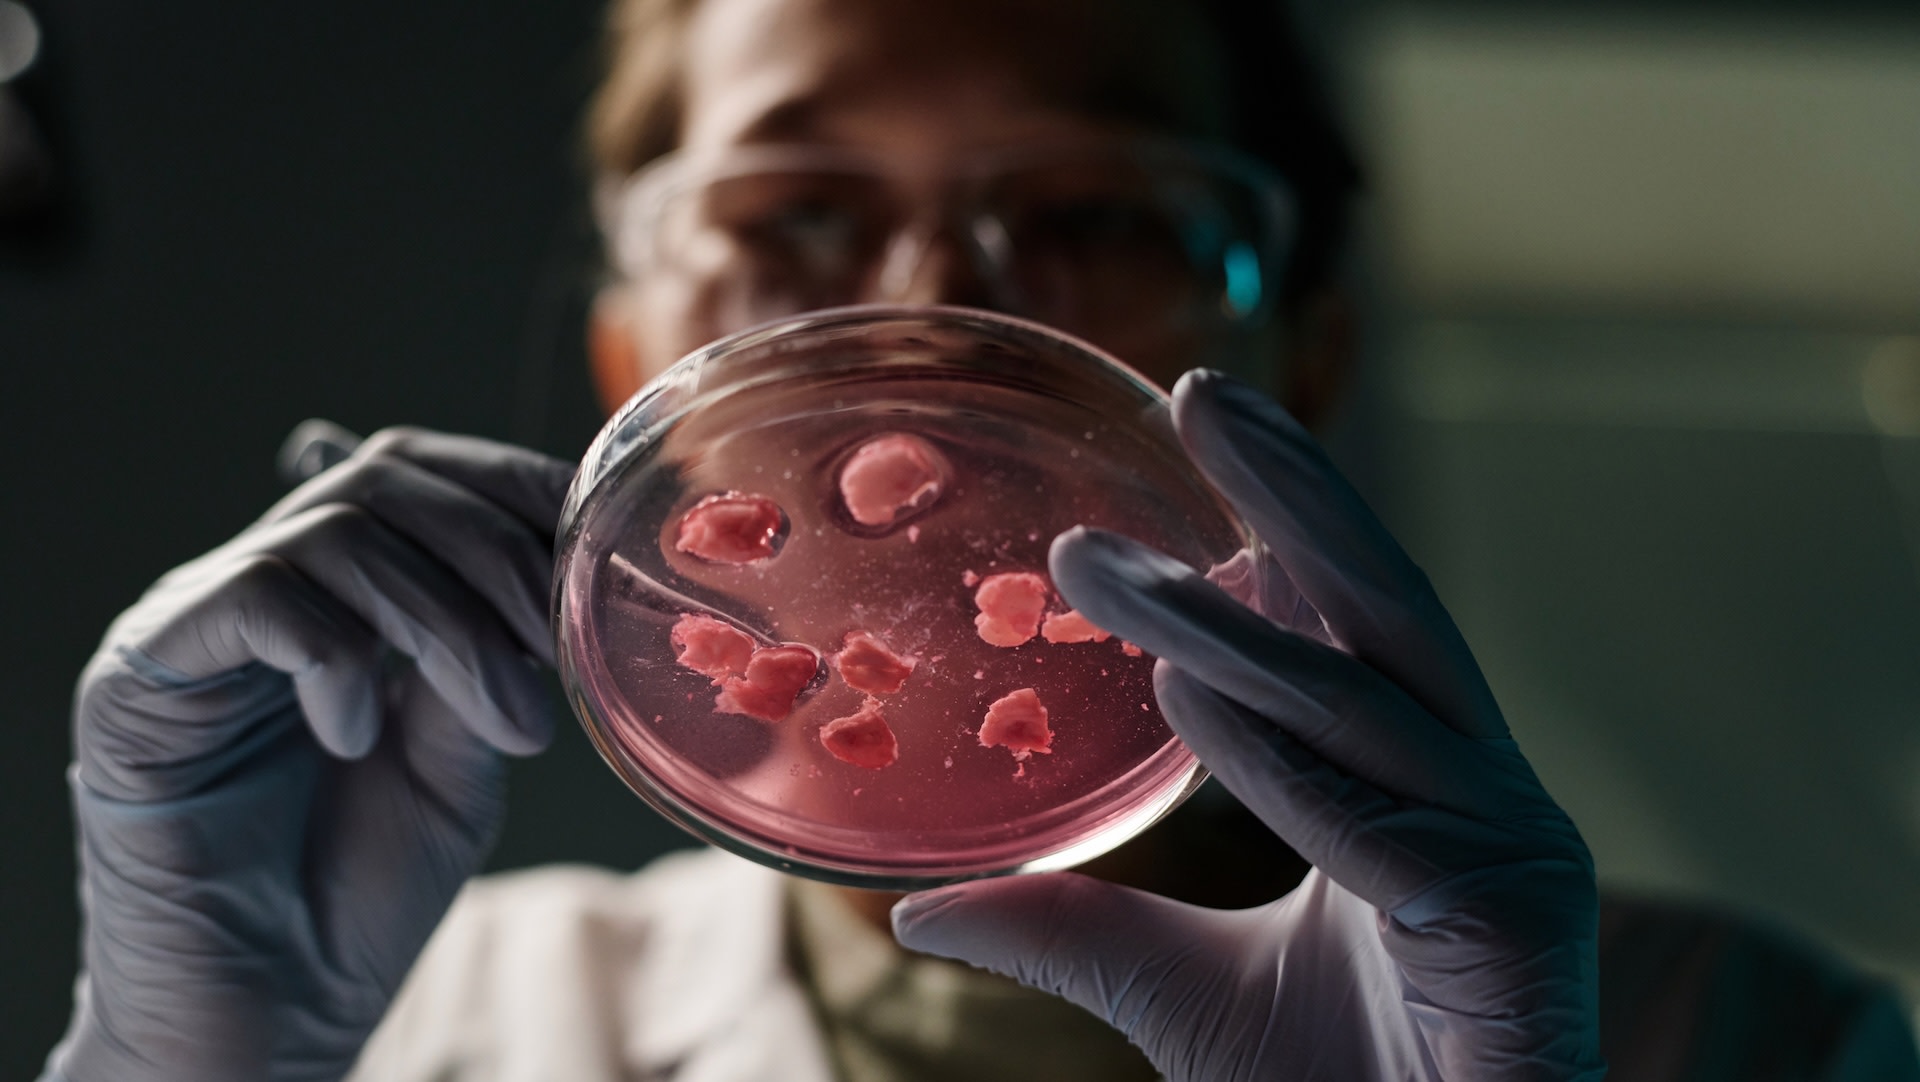

Microplastics can be found in clothes, food, and even water — but now, they have been found somewhere even more unsettling: inside the human brain. A recent report from the New York Times is making people think twice about how plastic exposure could be affecting their bodies in unexpected ways.
What's happening?
A behind-the-scenes look at a University of New Mexico lab revealed just how far microplastic particles may be traveling in the body.
A New York Times health reporter observed researchers using chemical tools to analyze plastic in human tissue samples.
One brain sample from 2024 contained nearly 5,000 micrograms of plastic per gram of tissue — an amount scientists estimate totals about 7 grams per brain, which is roughly the weight of a plastic spoon.
The team also tested common processed foods such as Spam and cheese slices for contamination and is currently studying how plastics affect brain function in mice.
"I already go out of my way to avoid single-use plastic, but I have made new efforts to reduce its contact with my food and body," the New York Times reporter wrote.
Why is this discovery concerning?
Microplastics, particles less than 5 millimeters in size, are already turning up in our meals, tap water, and air. The fact that they may be traveling into our brains raises major questions about the potential long-term effects on our health.
Early animal studies have linked microplastic exposure to gut damage, hormone disruption, and fertility issues. Now, researchers are looking at potential connections to dementia, heart disease, and premature birth.
These findings build on other recent reports that show plastic exposure is more widespread than many people realize.
One study revealed that bottled water can contain 100 times more microplastic particles than previously believed. Another showed that heating food in plastic containers can release harmful chemicals into your meals.
|
Do you worry about how much food you throw away? Click your choice to see results and speak your mind. |
What can I do to help reduce microplastic exposure?
It's tough to avoid plastic completely, but making small changes can still go a long way.
Choosing glass, stainless steel, or wood instead of plastic for storage or heating food is a good way to start. Heavily processed foods tend to carry more contamination, so limiting those when possible can also help.
Buying clothes made from natural fibers can also help reduce plastic shedding during laundry. Also, many brands are switching to plastic-free packaging for everyday products such as shampoo and detergent.
Join our free newsletter for weekly updates on the latest innovations improving our lives and shaping our future, and don't miss this cool list of easy ways to help yourself while helping the planet.